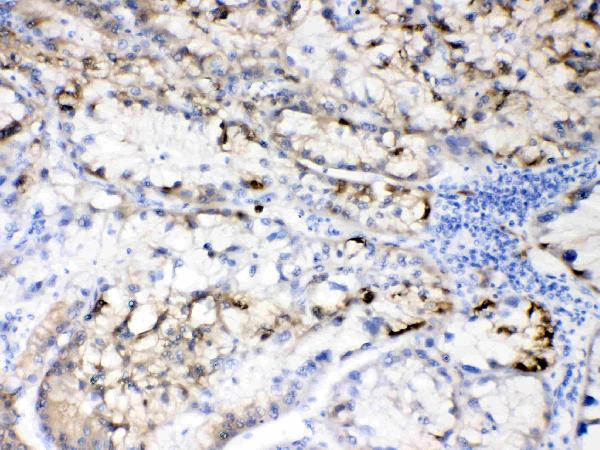
Figure 1. IHC analysis of Hepatitis B Virus using anti-Hepatitis B Virus antibody (A30379). Hepatitis B Virus was detected in paraffin-embedded section of human liver cancer tissues. Heat mediated antigen retrieval was performed in citrate buffer (pH6, epitope retrieval solution) for 20 mins. The tissue section was blocked with 10% goat serum. The tissue section was then incubated with 1microg/ml rabbit anti-Hepatitis B Virus Antibody (A30379) overnight at 4°C. Biotinylated goat anti-rabbit IgG was used as secondary antibody and incubated for 30 minutes at 37°C. The tissue section was developed using Strepavidin-Biotin-Complex (SABC)(Catalog # SA1022) with DAB as the chromogen. Figure 1. IHC analysis of Hepatitis B Virus using anti-Hepatitis B Virus antibody (A30379). Hepatitis B Virus was detected in paraffin-embedded section of human liver cancer tissues. Heat mediated antigen retrieval was performed in citrate buffer (pH6, epitope retrieval solution) for 20 mins. The tissue section was blocked with 10% goat serum. The tissue section was then incubated with 1microg/ml rabbit anti-Hepatitis B Virus Antibody (A30379) overnight at 4°C. Biotinylated goat anti-rabbit IgG was used as secondary antibody and incubated for 30 minutes at 37°C. The tissue section was developed using Strepavidin-Biotin-Complex (SABC)(Catalog # SA1022) with DAB as the chromogen.

Figure 2. IHC analysis of Hepatitis B Virus using anti-Hepatitis B Virus antibody (A30379). Hepatitis B Virus was detected in paraffin-embedded section of human hepatitis B tissues. Heat mediated antigen retrieval was performed in citrate buffer (pH6, epitope retrieval solution) for 20 mins. The tissue section was blocked with 10% goat serum. The tissue section was then incubated with 1microg/ml rabbit anti-Hepatitis B Virus Antibody (A30379) overnight at 4°C. Biotinylated goat anti-rabbit IgG was used as secondary antibody and incubated for 30 minutes at 37°C. The tissue section was developed using Strepavidin-Biotin-Complex (SABC)(Catalog # SA1022) with DAB as the chromogen.
Anti-Hepatitis B Virus Antibody Picoband(r)
A30379-CARRIER-FREE
ApplicationsWestern Blot, ImmunoHistoChemistry
Product group Antibodies
ReactivityHuman, Virus
TargetS
Overview
- SupplierBoster Bio
- Product NameAnti-Hepatitis B Virus Antibody Picoband(r)
- Delivery Days Customer9
- Application Supplier NoteTested Species: In-house tested species with positive results. By Heat: Boiling the paraffin sections in 10mM citrate buffer, pH6.0, for 20mins is required for the staining of formalin/paraffin sections. Other applications have not been tested. Optimal dilutions should be determined by end users.
- ApplicationsWestern Blot, ImmunoHistoChemistry
- CertificationResearch Use Only
- ClonalityPolyclonal
- Concentration500 ug/ml
- Gene ID944569
- Target nameS
- Target descriptionlarge envelope protein;middle envelope protein;small envelope protein
- Target synonymsHBVgp2, large envelope protein;middle envelope protein;small envelope protein
- HostRabbit
- IsotypeIgG
- Protein IDD2X4M3
- Protein NameLarge S protein
- Scientific DescriptionBoster Bio Anti-Hepatitis B Virus Antibody Picoband® catalog # A30379. Tested in IHC, WB applications. This antibody reacts with Human. The brand Picoband indicates this is a premium antibody that guarantees superior quality, high affinity, and strong signals with minimal background in Western blot applications. Only our best-performing antibodies are designated as Picoband, ensuring unmatched performance.
- ReactivityHuman, Virus
- Storage Instruction-20°C,2°C to 8°C
- UNSPSC12352203